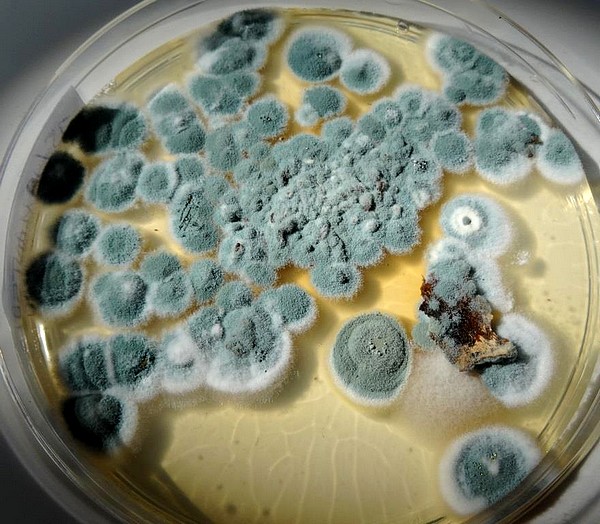

Identification des champignons lignivores |
|
A
|
Déterminer lespèce de champignon attaquant les bâtiments est fondamental dans le domaine de la construction, notamment la construction bois, puisque du type de champignon va dépendre le mode de traitement à engager.
Certes il est possible de poser un premier diagnostic lors des expertises, cependant, des analyses en laboratoire restent bien plus souvent nécessaires. |
|

| | 
|
Mérule pleureuse
Serpula lacrymans | | Mérule pleureuse
Serpula lacrymans |

| | 
|
Pleurote Pleurotus cornucopiae | | Lenzite du Sapin Gloeophyllum abietinum |

| | 
|
Polypore des caves Donkioporia expansa | | Polypore des caves Donkioporia expansa |

| | 
|
Lenzite des poutres Gloeophyllum sepiarium | | Lenzite des poutres Gloeophyllum sepiarium |

| | 
|
| Dydimium spp | | Polypore variable
|

| | 
|
Tramète versicolore (Trametes versicolor)
| | Pores de Tramète versicolore (Trametes versicolor) |

| | 
|
Rhizomorphes de Mérule au travers de maçonneries
(Serpula lacrymans) | | Hyménium mérulioïde de Mérule
(Serpula lacrymans) |

| | 
|
Champignon lignivore
| |
Champignon lignivore
|

| | 
|
Sparassis crépu
(Sparassis crispa) | | Lenzite du Sapin
(Gloeophyllum abietinum) |
|
|
A
|
Après réception des échantillons de champignons et dans le cas où les éléments différenciateurs sont insuffisamment développés, ceux-ci sont mis en culture en boite de pétri sur des milieux nutritifs sélectifs afin d'éviter le développement de champignons opportunistes. Cette première étape nous permet d'optimiser nos chances d'obtenir les éléments essentiels pour la diagnose finale. |
|
A
|

| | 
| |
|
|
Culture après 48h
| |
Culture à 96h
| |
Culture à 120h
|
|
|
|
A
Différents développements de moisissures après mise en culture (8jours) |
|
|
|
Le développement du champignon sur milieu nutritif va permettre de mettre en évidence le système hyphal, celui-ci constituant l'un des éléments déterminants pour poser un diagnostic.
Pour rappel : le système hyphal est composé d'hyphes. Ce sont des filaments formant l'appareil végétatif qui permettent au champignon de trouver dans le bois les éléments nutritifs nécessaires à son développement.
Chaque champignon possède un système hyphal qui lui est propre.
Il existe 3 types d'hyphes :
- hyphe génératif en forme de Y - hyphe squelettique - hyphe conjonctif
Le système hyphal est ainsi défini par sa composition en hyphes :
- monomitique (génératifs) - dimitique (génératifs et squelettiques) - trimitique (génératifs, squelettiques et conjonctifs)
Les hyphes peuvent être bouclés ou non (présence d'anse d'anastomose) et septés ou non (présence de cloison). Ces caractéristiques aident aussi lors de la détermination de l'espèce.
|
|

| | 
|
Hyphe génératif
(x 1000)
| |
Septum
(x 1000)
|
|

| | 
| | 
|
Boucle verticillée
(x1000)
| |
Anse d'anastomose (boucle)
(x 1000)
| |
Hyphe squelettique
(x 400)
|
|
| | 
| | 
| | 
|
| |
Hyphe bouclé et ramifié
(x 400)
| |
Astérophyse
(x 400)
| |
Baside à 2 stérigmates visibles
(x 1000)
|
|
|
A
|
Les spores sont également analysées. Celles-ci constituent l'organe de reproduction du champignon. Elles sont disséminées dans l'air à maturité.
A l'instar des hyphes, elles présentent une forme, une taille, une ornementation et des réactions différentes pour chaque espèce de champignon lignivore.
Celles-ci peuvent être rondes, elliptiques, ovoïdes, guttulées, etc.et leur taille varie de 4 à 14 microns selon les espèces. Les ornementations sont variées: réticule, verrue, lisse, etc. Enfin, la réaction signifie que certaines se colorent ou changent de forme selon le réactif dans lequel elles ont été plongées.
|

| | 
| | 
|
Spores de Mérule
(x 1000)
| |
Spores de Coniophore
(x 400)
| |
Spores et hyphes de Mérule
(x 400)
|
|

| | 
|
Asque à 8 ascospores de Pézize
(x 1000)
| |
Conidiophore de Penicillium
(x 600)
|
|

| | 
|
Conidiophores
(x 400)
| |
Clamydospore de Trichoderma viride
(x 400)
|
|

| | 
|
Spores de Lenzite
(x 1000)
| |
Conidie d'Alternaria
(x 400)
|
|
|
A
|
Certaines préparations fongiques font apparaître des cristaux d'oxalate de calcium.
Ceux-ci sont produits par certaines espèces de champignons ayant la capacité de sécréter de l'acide oxalique qui dissout les matériaux de type plâtre à forte concentration de calcium. |

|
|
Cristaux d'oxalate de calcium grossis 1000 fois
|
|
|
A
|
LE PLUS D'ABARCO LABORATOIRE
Même si nous ne disposons pas de tous les prélèvements nécessaires aux analyses, nous recherchons activement des éléments pertinents pour a minima exclure certaines espèces et au mieux, déterminer l'espèce de champignon actif.
NOTRE CREDO : FOURNIR DES RÉSULTATS TANGIBLES ET UTILES A LA DÉTERMINATION DES MESURES RÉPARATOIRES. |
|
|